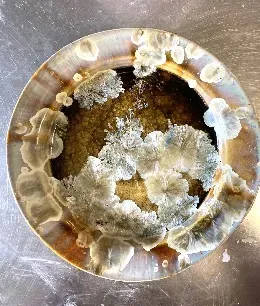

Artworks On Harmon
ARTWORKS ON HARMON is the new art gallery and studio for Harriet Zabusky-Zand located in Savannah, GA. There you can find all of the paintings, prints and pastels shown on www.harrietzzartist.com as well as beautiful, colorful crystalline glazed ceramics. Discover the perfect gift, or treat yourself.

LOCATION:
2205 Harmon Street
Savannah. GA 31401
(508) 737-0945
HOURS OF OPERATION:
Tuesday-Friday - 2:00 PM-6:00 PM
Saturday – 11:00 AM – 3:00 PM
Sunday-Monday – Closed
Or by appointment by calling (508) 737-0945



















